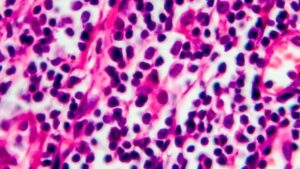

Noticias publicadas el 20 de septiembre de 2024
Aunque Vox siga al quite del sanchismo, incluso en lo del cupo catalán, el PP ha de permanecer firme en lo acordado: la multilateralidad. Cuando el sanchismo pone tanto interés en quebrar, como sea, tan inteligente estrategia, es que el PP ha acertado plenamente. No deseamos Judas frente a la misma. Deseamos firmeza en su […]
Meliá Hotels International inauguró este jueves la Casa de las Artes Meliá Collection, su cuarto hotel de lujo en Madrid, tras una inversión superior a 15 millones de euros para la transformación del edificio, antiguo Hotel Madrid Atocha, Affiliated by Meliá. 224
Penúltima y emocionante jornada del Sandberg Estates J/70 Worlds. Con todo visto para sentencia, la flota ya ha tomado posiciones de cara al asalto final y el “Yonder” norteamericano se aferra al liderato de la cita que organizan el Real Club Náutico de Palma y la Asociación Internacional de la clase J/70. 42
El pasado 14 de septiembre se celebró el Día Mundial de la Dermatitis Atópica. Esta es una enfermedad crónica e inflamatoria de la piel que aparece con frecuencia en los pacientes infantiles, de acuerdo con lo expuesto por el Instituto Nacional de Artritis y Enfermedades Musculoesqueléticas y de la Piel de Estados Unidos. 102
Linfoma es un término amplio que describe un cáncer que comienza en las células del sistema linfático. Desde la Fundación Josep Carreras explican que el sistema linfático “es una red de órganos (bazo y timo), ganglios linfáticos, conductos y vasos linfáticos que producen y transportan linfa desde los tejidos hasta el torrente sanguíneo”. Se trata […]
El alcalde de Calvià, Juan Antonio Amengual, junto a representantes de los colegios de Dietistas-Nutricionistas (Manuel Moñino), Psicólogos (Javier Torres) y licenciados en Educación Física (Carmen I. Vera), han firmado este viernes los primeros convenios para impulsar el trabajo de la Escuela Municipal de Hábitos Saludables. El objetivo es promover la salud y el bienestar […]
Diversos actos –la celebración de la ‘Cursa de Son Ferriol’, que se celebrará este sábado, día 21 de septiembre, y de la ‘XXX Fira de Son Ferriol’, el domingo; además de la celebración el sábado en el centro de Palma de la Diada de la Movilidad– obligarán a cortes de tráfico y desvíos de autobuses […]
La Escuela Universitaria Adema ha presentado este viernes la primera Bienal de Arte Internacional Universitario en Mallorca que se celebrará en junio del año que viene, según han anunciado los responsables del centro durante la inauguración del el curso académico 2024/25 del Grado en Bellas Artes. 101
El vicepresidente segundo del Consell de Mallorca y conseller insular de Medio Ambiente, Medio Rural y Deportes, Pedro Bestard, ha abandonado su cargo en el Comité Ejecutivo de Vox en Baleares. 435
Javier Bardem iniciará en enero el rodaje de una película con Rodrigo Sorogoyen -director de la multipremiada ‘As Bestas’- titulada ‘El ser querido’ y protagonizada también por la mallorquina Victoria Luengo. El intérprete de ‘No es país para viejos’, que este viernes recogerá el Premio Donostia del festival de cine internacional de San Sebastián, explicó […]
El Servicio de Emergencias 112 ha activado el Índice de Gravedad 1 (IG1) del Plan Meteobal por lluvias y tormentas en todas las Islas que podrían ir acompañadas de rachas muy fuertes de viento (entre 70 y 120 km/h), ‘caps de fibló’ y granizo. 335
Los empresarios de Mallorca sufren una caída en la facturación del 10 al 30 por ciento en los meses de temporada alta turística, una situación atribuida al aumento de precios y al impacto de las manifestaciones contra la masificación turística. Ocio, distribuidores, restauradores… todos coinciden en el diagnóstico. El sector hotelero, por su parte, muestra […]